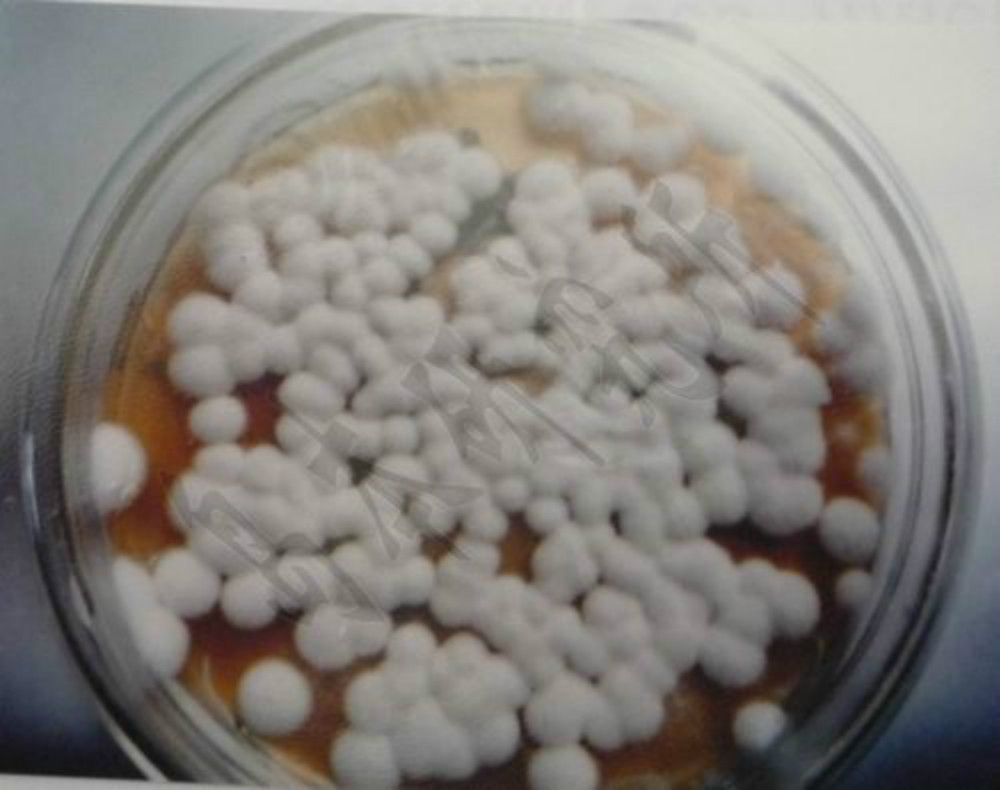
p>淡紫拟青霉((paecilomyces lilacinus(thorn.

淡紫紫孢菌

紫蘑菇
图片尺寸1650x1367![这个可以吃吗? 紫色蘑菇[偷笑]](https://i.ecywang.com/upload/1/img2.baidu.com/it/u=3418883145,2322941248&fm=253&fmt=auto&app=120&f=JPEG?w=800&h=844)
这个可以吃吗? 紫色蘑菇[偷笑]
图片尺寸1213x1280
具体是涉及一株淡紫紫孢菌及其烟草促生长生物菌剂制备方法及其应用
图片尺寸1000x958
这种生长在野外紫色的是什么蘑菇,有毒吗?
图片尺寸450x338
这种紫色的蘑菇叫什么名字?
图片尺寸579x502
紫色的蘑菇求问品种
图片尺寸1080x1439
紫色蘑菇
图片尺寸500x888
正远绿陇淡紫紫孢菌微生物菌剂根结线虫有益菌促根护根 淡紫拟青霉1kg
图片尺寸800x800
发现一种紫色的菌,不知道是什么求出处,是否有毒
图片尺寸960x720
紫白色的蘑菇有毒吗?
图片尺寸612x816
紫花菌
图片尺寸750x942
云南山林现紫色野生菌绽放后颜色由淡紫变淤青
图片尺寸660x594
慢慢的,慢慢的,野生菌生长的脚步近了!为了美味,先学点常识!
图片尺寸640x480
野生紫蘑菇
图片尺寸1200x972
紫色蘑菇.手机照片
图片尺寸900x1200
25,球孢白僵菌孢子接触到虫体后,在适宜的温度和温度条件下萌发,生长
图片尺寸640x653
p>淡紫拟青霉((paecilomyces lilacinus(thorn.
图片尺寸1000x790
紫珊瑚菌
图片尺寸960x720
贺兰山野生紫蘑菇_meitu_4.jpg
图片尺寸600x400
活菌50亿淡紫拟青霉紫孢菌厂家直销农作物根结线虫毛囊用1000g袋
图片尺寸300x300
![这个可以吃吗? 紫色蘑菇[偷笑]](https://i.ecywang.com/upload/1/img2.baidu.com/it/u=3418883145,2322941248&fm=253&fmt=auto&app=120&f=JPEG?w=800&h=844)














![这个可以吃吗? 紫色蘑菇[偷笑]](https://pic.rmb.bdstatic.com/bjh/events/f4c444f4aeb826a04a6cbe95eaa94dad1803.jpeg@h_1280)